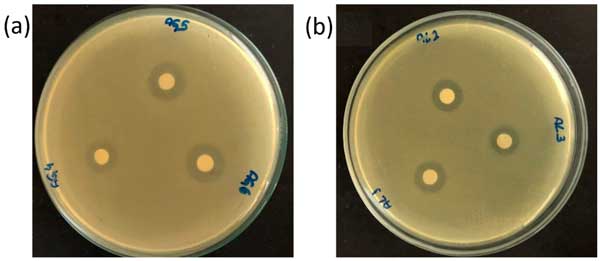

電話:13570151199
傳真:020-39972520
郵箱:hanyan@hanyancarbon.com
地址:廣東省廣州市番禺區(qū)東環(huán)街番禺大道北555號(hào)天安總部中心30號(hào)樓6層
活性炭浸漬大蒜提取物提升抗菌能力
病原微生物對(duì)水資源的污染是一個(gè)非常重要的問(wèn)題,比如,醫(yī)療產(chǎn)生的廢水含有多種化學(xué)和微生物污染物;钚蕴亢蜌⒕鷦┑慕Y(jié)合產(chǎn)生協(xié)同效應(yīng),在醫(yī)療廢水處理中具有巨大優(yōu)勢(shì)。換句話說(shuō),使用浸漬活性炭最大限度地減少了殺菌劑的直接使用,并結(jié)合了環(huán)境和經(jīng)濟(jì)效益。
大蒜提取物
新鮮生蒜瓣在1%次氯酸鈉溶液中消毒30分鐘,然后用蒸餾水徹底清洗。將清洗干凈的蒜瓣壓碎,用蒸餾水和乙醇兩種不同的溶劑進(jìn)行提取。應(yīng)該注意的是,蒜瓣沒(méi)有明顯的氣味。然而,粉碎后,由于大蒜素分解產(chǎn)生高濃度的硫化合物,產(chǎn)生了典型的硫磺氣味。此外,使用1g壓碎的大蒜手套和3mL溶劑進(jìn)行提取。每個(gè)懸浮液在5℃下保持24小時(shí)并通過(guò)3µm過(guò)濾器過(guò)濾。將提取物樣品冷凍直至立即用于浸漬步驟。
大蒜素是一種無(wú)色至淡黃色液體,含有微量元素硫。該分子及其衍生物使得精確的定量分析變得困難。然后,為了估計(jì)大蒜提取物中含硫化合物的濃度,測(cè)量了大蒜素濃度。通過(guò)測(cè)定孵育后的丙酮酸濃度來(lái)測(cè)量酶活性,從而對(duì)水提取物或醇提取物中的大蒜素進(jìn)行定量。由于大蒜素是一種揮發(fā)性且不穩(wěn)定的化合物,因此提取后立即獲得其濃度。
活性炭的酸官能化
首先,將活性炭用去離子水在323.15K下洗滌,并在333K下干燥24h。然后,將其研磨并過(guò)篩,粒度平均為0.180mm(70-100目ASTM)。懸浮的蘇活性炭溶液的pH為8.3。在200rpm和25℃下將20g活性炭添加到100mL各1molL-1酸溶液中后,用硝酸進(jìn)行官能化24小時(shí)。然后,過(guò)濾活性炭,用2L蒸餾水洗滌,并在48℃下干燥48小時(shí)。經(jīng)過(guò)硝酸處理的活性炭現(xiàn)在被命名為硝酸功能化碳。
活性炭和硝酸活性炭樣品中大蒜提取物的浸漬
浸漬是指化學(xué)物質(zhì)精細(xì)地分布在活性炭的內(nèi)表面上。這樣的過(guò)程促進(jìn)了這些物質(zhì)和固體之間的協(xié)同作用。在本文提出的研究中,將10g活性炭和硝酸活性炭樣品添加到100mL水性或酒精性大蒜提取物中,在180rpm下在室溫下保持24小時(shí)。然后,過(guò)濾懸浮液,并將碳樣品在干燥器中保存48小時(shí),并通稱為生物材料。在浸漬程序之后立即通過(guò)測(cè)量溶液中殘留的大蒜素來(lái)估計(jì)浸漬樣品的大蒜素組成。通過(guò)質(zhì)量平衡獲得活性炭樣品中浸漬的大蒜素的量。還研究了生物材料中大蒜素的釋放,以確保浸漬過(guò)程的成功。
活性炭樣品的表征
圖1a中所示的活性炭SEM圖像具有干凈、光滑的表面,具有明顯較小的空隙,正如對(duì)于相同的活性炭那樣。較小空隙的存在證實(shí)了其結(jié)構(gòu)特性。事實(shí)上,活性炭結(jié)構(gòu)中微孔的主導(dǎo)地位(高表面積SBET),典型的總體積(Vp)和平均孔徑(dp)。

圖1:活性炭樣品的SEM圖像(a)活性炭,(b)硝酸活性炭,(c)浸有水提取物的硝酸活性炭,(d)浸有水提取物和乙醇提取物的硝酸活性炭,放大1000倍。
微生物分析
使用體外微生物測(cè)定和大腸桿菌生長(zhǎng)抑制的證據(jù)評(píng)估了浸漬活性炭的抗菌潛力。通過(guò)圓盤(pán)擴(kuò)散進(jìn)行的抗菌敏感性測(cè)試顯示,在水中獲得的提取物的抑制暈圈為16±1.3mm,對(duì)于基于酒精的提取物為14±1.0mm,如圖2中的擴(kuò)散圓盤(pán)圖像所示。這種抑制是顯著的,證明了提取物在靜態(tài)介質(zhì)中的潛力。
圖2:通過(guò)紙片擴(kuò)散對(duì)(a)水基大蒜提取物,16±1.3mm和(b)乙醇基大蒜提取物,14±1.0mm進(jìn)行抗菌敏感性測(cè)試(從10次重復(fù)獲得的平均值和標(biāo)準(zhǔn)偏差值)。
圖3所示的圖像顯示了應(yīng)用提取物后對(duì)細(xì)菌生長(zhǎng)的抑制。經(jīng)過(guò)活性炭處理的廢水中未檢測(cè)到菌落,總共減少了5個(gè)對(duì)數(shù),這使得與活性炭相關(guān)的提取物成為潛在的殺菌劑。

圖3:活性炭樣品的微生物測(cè)試圖像(a)活性炭,(b)硝酸活性炭,(c)浸有水提取物的硝酸活性炭,(d)浸有氮功能化碳與乙醇提取物的硝酸活性炭。
大蒜含有具有廣泛生物活性的物質(zhì),包括抗菌作用。這項(xiàng)工作研究的水提取物和酒精提取物中所呈現(xiàn)的抗菌潛力可能與大蒜素的存在有關(guān),大蒜素是該食品中發(fā)現(xiàn)的主要活性植物化學(xué)物質(zhì)。類似的結(jié)果已經(jīng)表明大蒜素對(duì)一系列革蘭氏陽(yáng)性和革蘭氏陰性細(xì)菌(包括多重耐藥大腸桿菌菌株)具有抗菌作用。事實(shí)上,活性炭由于其化學(xué)穩(wěn)定性而被用作生物活性天然提取物的載體。這一特性對(duì)于使用浸漬有抗菌活性物質(zhì)的活性炭的廢水處理系統(tǒng)來(lái)說(shuō)是一個(gè)重要的盟友,其中病原體附著在生物材料上,隨后被提取物成分的作用所抑制。
活性炭浸漬大蒜提取物提升抗菌能力中,當(dāng)用硝酸功能化時(shí),活性炭為大蒜提取物中硫化合物的高電子帶電區(qū)域提供了有吸引力的表面。這意味著水提取物中的大蒜素和其他硫化合物被有效保留,并成功地成為一種殺菌固體材料,其抗菌活性在類似于廢水的合成污水中具有99.5%以上的大腸桿菌抗菌活性。通過(guò)綠色途徑合成的高效活性炭材料已被證明適用于去除水和廢水處理系統(tǒng)中的病原體,為醫(yī)療系統(tǒng)等復(fù)雜廢水的原位處理開(kāi)辟了新的前景。
文章標(biāo)簽:椰殼活性炭,果殼活性炭,煤質(zhì)活性炭,木質(zhì)活性炭,蜂窩活性炭,凈水活性炭.本文鏈接:http://www.gaminal.com/hangye/hy1232.html
查看更多分類請(qǐng)點(diǎn)擊:公司資訊 行業(yè)新聞 媒體報(bào)導(dǎo) 百科知識(shí)
推薦資訊
- 2025-11-27超細(xì)活性炭5000目粉末活性炭
- 2025-11-26活性炭在硫化橡膠襯套中的應(yīng)用
- 2025-11-19活性炭吸附重晶石混合物中的銅和鋅
- 2025-11-10活性炭去除PFAS
- 2025-11-03防一氧化碳霍加拉特劑
- 2025-11-03防汞蒸汽專用炭防放射性碘專用炭
- 2025-11-03防酸專用炭與防氨專用炭
- 2025-11-03防護(hù)服專用炭及全防炭的介紹應(yīng)用
- 2025-10-21活性炭從堿性甘氨酸溶液中吸附鉑
- 2025-10-10活性炭金屬改性對(duì)氫的吸附
- 2025-09-29活性炭吸附有機(jī)微污染物
- 2025-09-17活性炭去除對(duì)羥基苯甲醚
